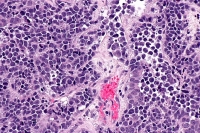

Curious Kids: how does electricity work?
Jul 10, 2019 06:51 am UTC| Science
Curious Kids is a series for children. If you have a question youd like an expert to answer, send it to [email protected] You might also like the podcast Imagine This, a co-production between ABC KIDS...

How solar heat drives rapid melting of parts of Antarctica's largest ice shelf
Jul 10, 2019 06:50 am UTC| Insights & Views Science
The ocean that surrounds Antarctica plays a crucial role in regulating the mass balance of the continents ice cover. We now know that the thinning of ice that affects nearly a quarter of the West Antarctic Ice Sheet is...

Neuroscience and artificial intelligence can help improve each other
Jul 10, 2019 03:10 am UTC| Insights & Views Technology Science
Despite their names, artificial intelligence technologies and their component systems, such as artificial neural networks, dont have much to do with real brain science. Im a professor of bioengineering and neurosciences...

Footprints on the Moon and cemeteries on Mars: interview with space archaeologist Alice Gorman
Jul 09, 2019 23:30 pm UTC| Insights & Views Science
Alice Gorman is a space archaeologist working on space junk in Earth orbit, deep space probes, and planetary landing sites. She explores what we can learn from these items and places as material objects, and also their...

HIV/AIDS cure 2019: Scientists successfully kills virus for first time on 'humanized mice'
Jul 09, 2019 11:33 am UTC| Science
Another significant development in the field of HIV cure study was reported recently. For the first time, scientists were able to kill the virus that causes AIDS on living mice by combining the use of CRISPR-Cas9 or CRISPR...
Cancer cure 2019: Promising development found on study focused on common cold virus
Jul 09, 2019 10:32 am UTC| Science
Many groups of scientists and researchers around the world are exploring various avenues in the hopes of finding a cure for cancer, and a potentially groundbreaking development was reported recently. A study may have...

Flying on Saturn’s moon Titan: what we could discover with NASA's new Dragonfly mission
Jul 07, 2019 15:16 pm UTC| Insights & Views Science
Flying on other worlds is the next leap in the exploration of our solar system. The Mars Helicopter will piggyback on the NASA Mars 2020 rover mission to demonstrate the technology. But this is only the start. The real...